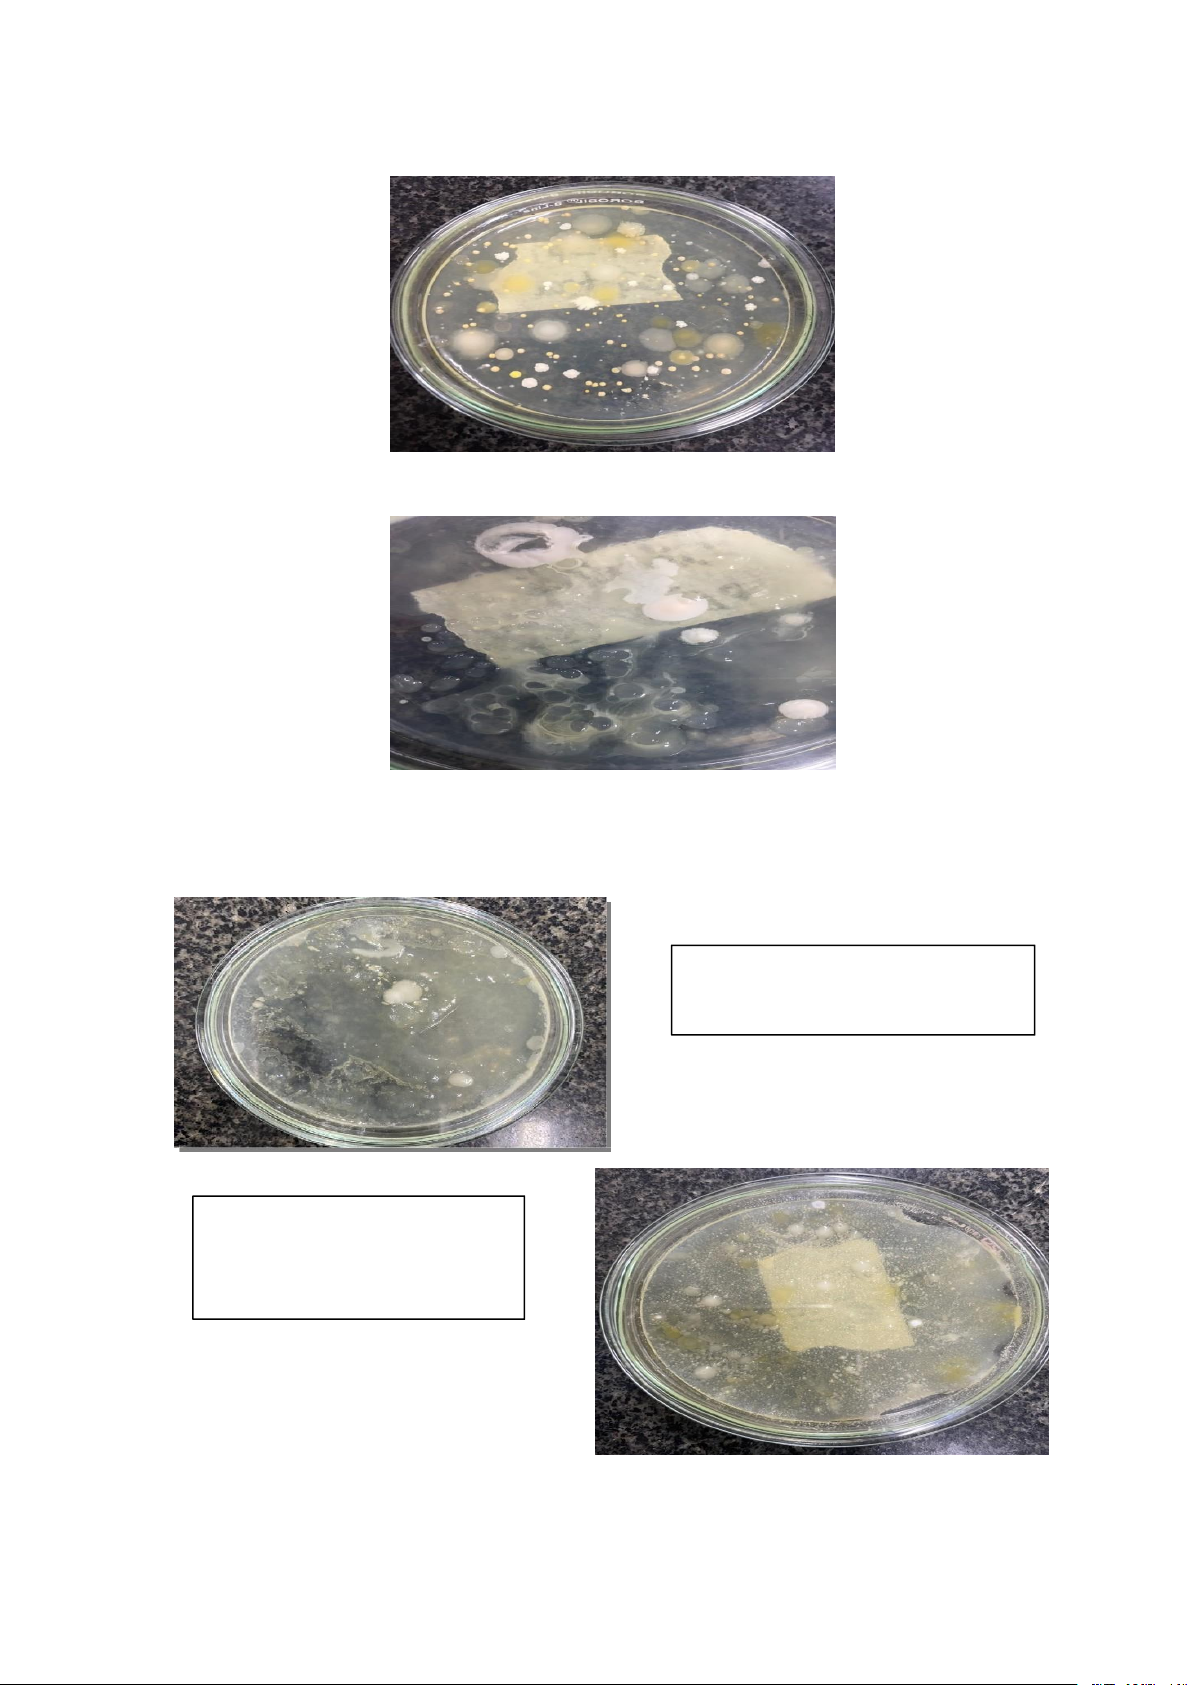

Preview text:
TRƯỜNG ĐẠI HỌC CÔNG NGHIỆP TP. HCM
VIỆN CÔNG NGHỆ SINH HỌC VÀ THỰC PHẨM
Baó cáo thực hành môn VI SINH VẬT HỌC
Đề tài: Phân lập, xác định thành phần và đặc điểm của
các chủng vi sinh vật trong mẫu
GVHD:Nguyễn Thị Lan Hương NHÓM SINH VIÊN: Nhóm 4 Lớp: DHTP17ATT TP. HCM, ngày tháng năm 1 Danh sách nhóm Tên sinh viên MSSV 2
Đề tài: Phân lập, xác định thành phần và đặc điểm của
các chủng vi sinh vật trong mẫu thực phẩm
I. Mục đích nghiên cứu của đề tài
- Là tách riêng các vi khuẩn từ quần thể ban đầu tạo thành các dòng vi
khuẩn thuần khiết (clon) được gọi là khuẩn lạc. Khi vi khuẩn tăng trưởng
và phát triển trên bề mặt môi trường rắn sẽ tạo ra những khuẩn lạc. Mỗi
nhóm vi khuẩn, mẫu loại vi khuẩn có hình thái tính chất khuẩn lạc khác
nhau, đặc trưng từng loại. II. Nguyên tắc
- Phân lập vi khuẩn là 1 quá trình tách rời một loại vi sinh vật từ quần thể
vi sinh vật, sau đó gieo chúng lên bề mặt thạch dinh dưỡng chọc lọc. Sau
đó ủ ở điều kiện thích hợp, các vi sinh vật tách riêng biệt gọi là khuẩn lạc.
- Chủng vi sinh vật thuần khiết ( hay gọi là chủng sạch) được hiểu là thế hệ
con, cháu có dòng từ một tế bào riêng lẻ. Các chủng vi sinh vật được thu
nhận từ khuẩn lạc lần đầu chưa chắc đã thuần khiết vì chúng có thể hình
thành bởi 1 hoặc nhiều tế bào, vì thế phải làm sạch nhiều lần mới thu được
chủng vi sinh vật thuần khiết.
III. Phương pháp nghiên cứu
- Phương pháp pha chế môi trường dinh dưỡng nuôi cấy vi sinh vật
- Phương pháp nuôi cấy vi sinh vật
- Phương pháp quan sát vi sinh vật bằng kính hiển vi quang học
- Phương pháp nhuộm màu vi sinh vật
- Phương pháp phân lập vi sinh vật IV. Kết quả dự kiến
- Sau khi thực hiện đề tài thu được ít nhất 5 chủng vi sinh vật khác nhau,
trong đó có ít nhất 1 chủng nấm mốc, 1 chủng nấm men, 1 chủng vi khuẩn
gram (+), 1 chủng vi khuẩn gram (-), 1 chủng cầu khuẩn.
V. Tài liệu tham khảo :Thực tập Vi sinh vật học 3 Mục lục Kế hoạch thực hiện đề
tài. . . . . . . . . . . . . . . . . . . . . . . . . . . . . . . . . . . . . . . . . . . . . . . . . . . . . . . . . . . . . . .5
Buổi 1. Pha chế môi trường dinh dưỡng nuôi cấy vi sinh vật. . . . . . . . . . . . 6
Mục đích. . . . . . . . . . . . . . . . . . . . . . . . . . . . . . . . . . . . . . . . . . . . . . . . . . . 6
Nguyên tắc. . . . . . . . . . . . . . . . . . . . . . . . . . . . . . . . . . . . . . . . . . . . . . . . . 6
Tiến hành thí nghiệm. . . . . . . . . . . . . . . . . . . . . . . . . . . . . . . . . . . . . . . . . 6
Buổi 2. Cấy phân lập bằng phương pháp cấy hộp trải và hộp đổ. . . . . . . .10
Mục đích. . . . . . . . . . . . . . . . . . . . . . . . . . . . . . . . . . . . . . . . . . . . . . . . . .10
Nguyên tắc. . . . . . . . . . . . . . . . . . . . . . . . . . . . . . . . . . . . . . . . . . . . . . . . 10
Chuẩn bị dụng cụ. . . . . . . . . . . . . . . . . . . . . . . . . . . . . . . . . . . . . . . . . . . 10
Tiến hành thí nghiệm. . . . . . . . . . . . . . . . . . . . . . . . . . . . . . . . . . . . . . . . 10
Kết quả và biện luận kết quả. . . . . . . . . . . . . . . . . . . . . . . . . . . . . . . . . . 12
Buổi 3. Cấy truyền làm thuần và quan sát vi sinh vật dưới kính hiển vi. . 13
Nguyên tắc của cấy truyền làm thuần. . . . . . . . . . . . . . . . . . . . . . . . . . . 13
Mục đích của cấy truyền làm thuần. . . . . . . . . . . . . . . . . . . . . . . . . . . . .13
Nguyên tắc của kính hiển vi. . . . . . . . . . . . . . . . . . . . . . . . . . . . . . . . . . .13
Cấu tạo của kính hiển vi. . . . . . . . . . . . . . . . . . . . . . . . . . . . . . . . . . . . . .13
Tiến hành thí nghiệm. . . . . . . . . . . . . . . . . . . . . . . . . . . . . . . . . . . . . . . . 14
Buổi 4: Cấy truyền làm thuần và nhuộm màu vi sinh vật. . . . . . . . . . . . . 17
Mục đích. . . . . . . . . . . . . . . . . . . . . . . . . . . . . . . . . . . . . . . . . . . . . . . . . .17
Nguyên tắc. . . . . . . . . . . . . . . . . . . . . . . . . . . . . . . . . . . . . . . . . . . . . . . . 17
Chuẩn bị dụng cụ. . . . . . . . . . . . . . . . . . . . . . . . . . . . . . . . . . . . . . . . . . . 18
Tiến hành thí nghiệm. . . . . . . . . . . . . . . . . . . . . . . . . . . . . . . . . . . . . . . . 18
Kết quả và biện luận kết quả. . . . . . . . . . . . . . . . . . . . . . . . . . . . . . . . . . 19
Buổi 5. Cấy giữ giống vi sinh vật trong ống nghiệm. . . . . . . . . . . . . . . . . 20
Mục đích. . . . . . . . . . . . . . . . . . . . . . . . . . . . . . . . . . . . . . . . . . . . . . . . . .20
Nguyên tắc. . . . . . . . . . . . . . . . . . . . . . . . . . . . . . . . . . . . . . . . . . . . . . . . 20
Tiến hành thí nghiệm. . . . . . . . . . . . . . . . . . . . . . . . . . . . . . . . . . . . . . . . 20
Kết quả và biện luận kết quả. . . . . . . . . . . . . . . . . . . . . . . . . . . . . . . . . . 21
Sơ đồ phân lập vi sinh vật. . . . . . . . . . . . . . . . . . . . . . . . . . . . . . . . . . . . . . 22 4
Kế hoạch thực hiện đề tài
Buổi 1. Pha chế môi trường dinh dưỡng
Buổi 2. Cấy phân lập bằng phương pháp cấy hộp trải và hộp đổ
Buổi 3. Cấy truyền làm thuần và quan sát vi sinh vật dưới kính hiển vi
Buổi 4. Cấy truyền làm thuần và nhuộm màu vi sinh vật
Buổi 5. Cấy giữ giống vi sinh vật trong ống nghiệm 5
Buổi 1. Pha chế môi trường dinh dưỡng nuôi cấy vi sinh vật I. Mục đích
-Tạo ra môi trường có đầy đủ chất dinh dưỡng cho vi sinh vật tồn tại và phát triển
-Đảm bảo sự cân bằng về áp suất thẩm thấu giữa môi trường và tế bào và phát triển
- Đảm bảo các điều kiện hóa lý cần thiết cho các hoạt động trao đổi của vi sinh vật. II. Nguyên tắc
- Môi trường dinh dưỡng là hỗn hợp gồm các chất dinh dưỡng và các chất
có nhiệm vụ duy trì thế oxy hóa - khử, áp suất thẩm thấu của tế bào và sự
ổn định độ pH của môi trường.
- Yêu cầu của môi trường dinh dưỡng: có đủ các chất dinh dưỡng cần thiết;
có độ pH thích hợp; có độ nhớt nhất định; không chứa các yếu tố đọc hại;
hoàn toàn vô trùng đảm bảo sự phát triển ổn định của vi sinh vật.
III. Tiến hành thí nghiệm
1. Chuẩn bị môi trường nuôi cấy vi sinh vật
- Chuẩn bị dụng cụ, hóa chất - Cân đong hóa chất + Riêng lẻ + Chính xác - Phối trộn hóa chất + Riêng lẻ + Theo trình tự - Đun sôi - Đo PH môi trường
- Phối trộn vào dụng cụ chứa ( erlen, ống nghiệm, bình thủy tinh, đỉa petri )
- Hấp tiệt trùng môi trường (121℃,30 phút,1 atm) - Đổ đĩa petri
2. Quy trình nuôi cấy vi sinh vật ( Môi trường PDA )
Bước 1: Chuẩn bị dụng cụ, hóa chất + 1 bình erlen + 1 becher + 12 đĩa petri + 5 ống nghiệm 6 + Khoai tây + Agar + Glucozo
Bước 2: Cân đong hóa chất + Khoai tây 30g + Agar 3g + Glucozo 3g + Nước cất 150ml
Hình ảnh cân đong hóa chất
Bước 3: Phối trộn hóa chất
+ Cho agar và glucozo vào becher trộn đều Bước 4: Đun sôi
+ Cho khoai tây và 150ml nước vào nồi đun sôi khoảng 15-20 phút.
+ Sau đó lấy nước luộc khoai tây
+ Tiếp theo cho nước vừa thu được vào hỗn hợp agar và glucozo, hòa tan.
+ Sau khi hòa tan,cho hỗn hợp vừa hòa tan đun sôi trên bếp cho đến khi hỗn hợp vừa sôi.
Bước 5: Đo PH môi trường
+ Muốn điều chỉnh độ pH của môi trường có thể dùng HCl 10% hay NaCl
10%. Ngoài ra có thể dùng một số hóa chất khác như: H3PO4, H2SO4, KOH, NaHCO3, Na2CO3. .
+ Muốn kiểm tra độ pH của môi trường nên dùng máy đo pH (pH-metre).
Phương pháp này nhanh nhạy và cho độ chính xác cao. Trong phòng thí
nghiệm có thể dùng chỉ thị màu xanh bromotomol hay giấy quỳ để đo pH.
Phương pháp này tiện lợi, nhanh nhưng không cho độ chính xác cao.
Bước 6: Phối trộn vào dụng cụ chứa môi trường 7
+ Cho hỗn hợp vừa hòa tan vào erlen 250 sau đó dùng giấy bạc đậy kín
miệng erlen cố định bằng băng dính hoặc dùng bông không thấm nước bịt
kính miệng erlen và dùng giấy báo bịt kín thêm lần nữa và cố định bằng dây thun. Hình ảnh đậy kín hỗn hợp vừa hòa tan bằng giấy bạc
Bước 7: Hấp tiệt trùng môi trường
+ Cho môi trường vào nồi hấp 30-45 phút, 121℃,1atm
+ Tiếp theo cho đĩa petri vào tủ sấy để tiệt trùng 180℃ 30 phút
Hình ảnh gói đĩa petri bằng giấy báo cho vào tủ
Bước 8: Đổ môi trường ra đĩa petri
+ Đổ môi trường ra 5 đĩa petri đã tiệt trùng 8 Hình ảnh đổ môi trường ra đĩa petri
+ Nhanh tay rót môi trường vào dụng cụ và đậy giấy bạc lại bình chứa.
+ Đối với đĩa petri, môi trường chỉ được phân phối vào đĩa sau khi đã hấp tiệt trùng.
Thể tích môi trường khoảng 12-15 ml mỗi đĩa, lớp môi trường thạch dày khoảng 2 mm.
+ Viết nhãn môi trường trên dụng cụ chứa, bao gồm các thông tin: Tên
môi trường, ngày khử trùng, người pha chế.
VI. Kết quả và biện luận kết quả
Đây là kết quả sau khi đổ môi trường vào đĩa
- Sau khi đổ môi trường PDA vào đĩa petri thì sau một thời gian nó sẽ đông
lại thành dạng thạch do có thành phần agar nên làm cho môi trường của
chúng ta đông lại.Để một vài ngày nếu không có sự xuất hiện của vi sinh
vật nào trên bề mặt môi trường vậy đã thành công. 9
Buổi 2. Cấy phân lập bằng phương pháp cấy hộp trải và hộp đổ I. Mục đích
- Tạo ra nhiều chủng VSV riêng rẽ trong môi trường , phục vụ cho các
công đoạn cấy chuyền làm thuần, quan sát hình thái đại thể , vi thể , nhuộm màu … II. Nguyên tắc
- Phân lập vi khuẩn là một quá trình tách rời một loại vi sinh vật từ quần
thể vi sinh vật, sau đó gieo chúng lên bề mặt môi trường thạch dinh dưỡng
chọn lọc. Sau khi ủ ở các điều kiện thích hợp, các vi vi sinh vật sẽ phân
chia nhiều lần tạo thành những quần thể mọc riêng biệt gọi là khuẩn lạc.
- Quá trình phân lập vi sinh vật ở dạng thuần khiết: với hầu hết các loại
mẫu nghiên cứu, quá trình phân lập vi sinh vật ở dạng thuần khiết gồm các bước cơ bản sau.
+ Lựa chọn nguồn phân lập vi sinh vật;
+ Tạo ra các khuẩn lạc riêng rẽ từ quần thể vi sinh vật ban đầu;
+ Phân lập vi sinh vật thuần khiết;
+ Kiểm tra độ tinh khiết của các khuẩn lạc. III. Chuẩn bị dụng cụ - Que cấy đầu tròn,móc - Đèn cồn - Que trải - Giá ống nghiệm - Cốc 100ml
- Môi trường nuôi cấy vi sinh vật: đã được chuẩn bị ở buổi 1 IV. Tiến hành thí nghiệm
1. Lựa chọn nguồn phân lập
a) Nguồn phân lập nấm mốc
- Một số chủng nấm mốc như Aspergillus oryzae, Aspergillus niger và
Mucor… có thể phân lập các loài nấm mốc này trên cơm nguội, xôi làm
mốc tương, bánh mì để khô ít ngày.
b) Nguồn phân lập nấm men
- Có thể phân lập nấm men dễ dàng từ các môi trường như: bề mặt trái cây
và dịch ép một số trái cây như táo, lê, nho, dâu, mơ, dứa, trong rượu nếp,
trong các bánh men rượu, trong bia, trong nước mía, trong hạt kefia.
c) Nguồn phân lập vi khuẩn
- Có thể phân lập vi khuẩn từ đất, nước giải khát (nước mía), nước thải,
thực phẩm tươi (thịt, cá, sữa tươi, rau quả tươi…), thực phẩm bị ôi thiu… 10
2. Kỹ thuật nuôi cấy tạo khuẩn lạc riêng lẽ từ quần thể vi sinh vật trên các môi trường phân lập
Bước 1: Xử lí mẫu, pha loãng mẫu hút lấy mẫu nước mía 1ml bằng
micropipett (pipette Pasteur) và hơ với lửa, sau đó cho vào 9ml Nacl 0,9%,
nước muối sinh lý. Lấy 1ml ống nghiệm 1 sang ống nghiệm 2 tương tự như
vậy tới ống nghiệm thứ 5. Trong suốt quá trình thực hiện phải gần đèn cồn.
Bước 2: Thực hiện cấy đổ và cấy trải
* Cấy đỗ trên thạch đĩa ( Cho mẫu vào đĩa peptri trước)
- Dùng micropipette và đầu tuýp vô trùng, hút 1 ml mẫu đã pha loãng ở ống
nghiệm 10⁵ vào đĩa petri.
- Tiếp theo,đổ khoảng 15-20 ml môi trường đã đun chảy và để nguội. Đổ môi trường vào mẫu
- Xoay nhẹ đĩa petri cùng chiều và ngược chiều kim đồng hồ vài lần để
dung dịch mẫu và môi trường trộn đều trong môi trường cấy.
* Cấy trải trên thạch đĩa ( Cho môi trường trước vào đĩa peptri trước)
- Dùng micropipette và đầu tuýp vô trùng, hút 0,1 ml mẫu đã pha loãng ở
ống nghiệm 10⁵ lên bề mặt môi trường trong đĩa petri.
- Sau đó dùng que trải thủy tinh nhúng vào cồn và hơ qua ngọn lửa đèn cồn
( thực hiện 3 lần), để nguội.
- Tay trái cầm hộp petri khẽ hơ nhẹ trên ngọn lửa đèn cồn. Sau đó để cách
đèn cồn chừng 1-2 cm, khẽ mở nghiêng một bên hộp (phần hơ lửa), sao cho
vừa đủ để cho que cấy vào.
- Nhẹ nhàng, nhanh chóng lướt que cấy trên mặt thạch theo một trong các kiểu sau:
+ Theo hình zích zắc trên toàn bộ mặt thạch.
+ Theo những đường song song.
+ Theo hình zích zắc 3 hoặc 4 góc. 11
V. Kết quả và biện luận kết quả
Đây là kết quả thu được, đĩa thứ nhất ta thấy những đóm vàng trên bề thạch đó là vi khuẩn.
Hình ảnh đĩa thứ hai, có xuất hiện đóm tròn màu trắng đục bề mặt khô ráo đó là nấm men.
Trong quá trình làm có những đĩa bị hỏng như
Đĩa này lí do bị hỏng là do
đổ môi trường không đều Đĩa này trong quá trình
thao tác do để sát đèn cồn,
làm cho môi trường bị tan 12
Buổi 3. Cấy truyền làm thuần và quan sát vi sinh vật dưới kính hiển vi
I. Nguyên tắc của cấy truyền làm thuần
- Sau khi thực hiện cấy phân lập , sau vài ngày sẽ xuất hiện các chủng VSV
trên đĩa petri . Ta thực hiện cấy chuyền làm thuần bằng phương pháp cấy
ria và cấy điểm qua một đĩa môi trường mới và thao tác này được lặp lại
nhiều lần cho đến khi VSV thuần khiết .
II. Mục đích của cấy truyền làm thuần
- Để tạo ra đồng nhất một chủng VSV thuần khiết từ một tế bào riêng lẽ ,
phục vụ cho các công đoạn nghiên cứu đặc điểm , hình thái , nhuộm màu của từng chủng VSV.
III. Nguyên tắc của kính hiển vi
- Dùng ánh sáng có bước sóng từ 500 nm – 560 nm trong chùm ánh sáng
thường để tạo năng suất phân ly lớn giúp phân biệt hai điểm cách nhau khoảng 0,2 µm trở lên.
- Chức năng của kính hiển vi quang học dùng để quan sát tế bào vi sinh vật,
ký sinh trùng, tế bào động vật, thực vật.
IV. Cấu tạo của kính hiển vi
Kính hiển vi quang học được cấu tạo gồm hai phần:
- Hệ thống cơ học: giá kính gồm chân kính, thân kính, trụ đỡ và xoay thị
kính, ổ gắn và xoay vật kính, bàn kính, thanh trượt di chuyển tiêu bản, ốc di
chuyển thanh trượt, kẹp giữ tiêu bản, ốc di chuyển tụ quang kính, ốc điều
chỉnh sơ thô cấp, ốc điều chỉnh thứ cấp (vi cấp).
- Hệ thống quang học gồm: thị kính, vật kính, tụ quang kính, màn chắn
sáng, nguồn chiếu sáng (đèn điện chiếu sáng và/ hoặc kính chiếu sáng). 13
Ngoài ra, ở kính dùng nguồn chiếu sáng là đèn điện thì có thêm bộ phận
cung cấp điện như phích cắm, dây điện, cầu chì, mạch điện (trong chân
kính) và nút điều chỉnh cường độ chiếu sáng. V. Tiến hành thí nghiệm 1. Cấy truyền làm thuần
- Sau khi cấy phân lập ở bước 1 ,bước 2 , vài ngày sau đĩa petri có các chủng VSV khác nhau .
- Cấy vi sinh vật từ khuẩn lạc mọc tách rời trên đĩa petri vào một đĩa petri
khác đã chuẩn bị sẵn môi trường.
- Nuôi vi sinh vật ở nhiệt độ và thời gian thích hợp.
- Loại bỏ các đĩa petri bị nhiễm, chọn ra các đĩa petri có các chủng thuần khiết
- ( Cấy ria )cấy truyền bằng que cấy đầu tròn đối với vi khuẩn và nấm men :
+ Dùng que cấy vòng thao tác vô trùng ( Vi khuẩn và nấm men )
+ Ria các đường trên đĩa pêtri chứa môi trường thích hợp (ria chữ T và ria bốn góc).
Sau mỗi đường ria, đốt khử trùng đầu que cấy và làm nguội trước khi thực
hiện đường ria tiếp theo. Hình ảnh cấy truyền bằng ria chữ T
- ( Cấy điểm ) cấy truyền bằng que cấy đầu mốc đối với nấm mốc
+ Dùng que cấy mốc thao tác vô trùng ( nấm mốc )
+ Cấy một điểm vào trong lòng thạch hoặc ba điểm theo hình tam giác đều Hình ảnh về cấy truyền bằng phương pháp cấy điểm 14
2. Quan sát kính hiển vi ( quan sát vi sinh vật ở buổi 2)
Trước khi sử dụng phải kiểm tra tất cả các bộ phận của kính, dùng khăn
mềm để lau các bộ phận của kính để kính ngay ngắn vừa với tầm ngồi. Sau
đó cần thao tác các bước sau:
* Bước 1: Chuẩn bị kính
Kết nối kính hiển vi với nguồn điện , bật công tắc kính, điều khiển nút
chỉnh ánh sáng để kính để có được ánh sáng thích hợp.
* Bước 2: Đặt tiêu bản vào mâm kính
- Trước khi đặt tiêu bản vào mâm kính, phải chọn mặt phải, mặt trái của
tiêu bản.Mặt phải của tiêu bản thường có dán lamen, dán nhãn (nếu có
lamen và nhãn) hoặc làm giảm bớt độ lóa của gương khi để nghiêng soi ra
ánh sáng (nếu không có lamen, không có nhãn)
- Để mặt phải của tiêu bản lên trên, tay phải mở kẹp tiêu bản, tay trái cầm
phía đầu nhãn tiêu bản, đặt tiêu bản vào mâm kính và tay phải thả kẹp giữ
tiêu bản ra. Tiêu bản được giữ chặt vào xe đẩy, trên mâm kính.
- Dùng ốc xe đẩy để điều chỉnh sao cho mẫu vật nằm đúng vào trục kính * Bước 3: Quan sát
Nguyên tắc bắt buộc khi quan sát là phải quan sát được ở vật kính có độ
phóng đại nhỏ, rồi mới chuyển sang quan sát ở vật kính có độ phóng đại lớn hơn kề nó.
Xem tiêu bản ở vật kính x10
- Hạ tụ quang kính xuống dưới (tức tăng khoảng cách tụ quang với tiêu
bản, thị trường mờ đi).
- Xoay vật kính x10 vào khớp của ổ đỡ vật kín.
Mắt nhìn vào bàn đặt tiêu bản (không nhìn vào thị kính), hai tay xoay ốc
điều chỉnh sơ cấp đưa dần vật kính hướng đến tiêu bản (không được chạm vào tiêu bản).
- Đặt mắt hướng vào thị kính, hai tay xoay chậm ốc điều chỉnh sơ cấp
hướng ra xa tiêu bản đến khi mắt thấy rõ dần tiêu bản mẫu vật thì dừng lại.
Hai tay nắm ốc vi cấp điều chỉnh cho ảnh rõ nhất.
- Mắt vẫn hướng vào thị kính, điều chỉnh một lần nữa khoảng cách của tụ
quang kính với tiêu bản và màn chắn sáng sao cho ảnh rõ nhất.
Xem tiêu bản ở vật kính x40
- Nâng tụ quang kính lên vừa phải (thị trường sáng hơn).
- Xoay vật kính x40 vào khớp của ổ đỡ vật kính (hướng vật kính vào tụ quang).
- Đặt mắt hướng vào thị kính, có thể nhìn thấy ngay hình thái của mẫu vật.
Hai tay nắm ốc vi cấp điều chỉnh cho ảnh rõ nhất.
- Mắt vẫn hướng vào thị kính, điều chỉnh một lần nữa khoảng cách của tụ
quang kính với tiêu bản và màn chắn sáng sao cho tiêu bản thấy ảnh rõ nhất Quan sát vi sinh vật
- Xem chi tiết hình dáng, màu sắc của nấm mốc: khuẩn ty, vách ngăn khuẩn
ty,cuống bào tử, thể bọng, thể bình, túi bào tử, cách sắp xếp của bào tử. .
Xem tổng thể hình dáng của nấm mốc ở vật kính x10. 15
- Tế bào nấm men: Xem ở vật kính x40 quan sát hình dạng tế bào: tế bào
đứng riêng lẻ hay kết dính tạo sợi giả - sợi thật, trạng thái nảy chồi. Vẽ hình
một thị trường kính hiển vi ở vật kính X40, có các tế bào nấm men.
- Xem trạng thái của tế bào vi khuẩn: di động hay đứng yên, kiểu di động
của tế bào, hình dạng của tế bào.
VI. Kết quả và biện luận kết quả Hình ảnh của vi
Hình ảnh nấm men,nhìn nó dày vì lấy vi sinh nhiều
Hình ảnh thu được khi cấy truyền môi
trường PDA,ta thấy có màu tím là do vi sinh 16
Buổi 4: Cấy truyền làm thuần và nhuộm màu vi sinh vật I. Mục đích
+ Giúp việc quan sát hình dạng tế bào, các thành phần cấu trúc tế bào
của vi sinh vật được dễ dàng.
+ Giúp phân biệt các chủng vi sinh vật với nhau do việc ăn màu khác
nhau đối với các loại thuốc nhuộm tạo điều kiện cho việc phân loại,
định dạng vi sinh vật ( nhuộm màu Gram) II. Nguyên tắc
- Nhuộm màu là quá trình làm cho tế bào hoặc các thành phần của tế bào
vi sinh vật có màu dưới tác dụng của các loại thuốc nhuộm.
- Tùy theo từng loại vi sinh vật, tùy theo từng cấu trúc tế bào muốn
nhuộm, ta có nhiều phương pháp nhuộm màu khác nhau. Mỗi phương pháp
nhuộm cũng có nguyên tắc nhuộm khác nhau.
- Đối với các phương pháp nhuộm màu vi sinh vật được cố định, thường
sử dụng thuốc nhuộm có khả năng thẩm thấu qua màng tế bào và kết hợp
với thành phần khác nhau của tế bào thành những hợp chất màu đặc trưng bền vững. III. Chuẩn bị dụng cụ - Đèn cồn - Bình tia - Que cấy - Kính hiển vi - Chậu thủy tinh - Phiến kính - Lá kính - Cốc 100ml - Nước mía - Các dung dịch nhuộm + Dung dịch xanh methylen
+ Dung dịch tím kết tinh (crystal violet) + Dung dịch lugol + Cồn
+ Dung dịch nhuộm bổ sung IV. Tiến hành thí nghiệm * Nhuộm đơn
- Quy trình nhuộm đơn cần chuẩn bị một số dụng cụ sau: đèn cồn, que
cấy, kính hiển vi, lam kính,…
- Nhuộm đơn là dùng 1 loại thuốc nhuộm để nhuộm. Các loại thuốc
nhuộm thường dùng để nhuộm đơn là: + Fuchsin kiềm. + Xanh metylen. 17 + Tím gentian. + Đỏ trung tính.
- Phương pháp nhuộm: đặt tiêu bản đã cố định lên giá rồi nhỏ vài giọt
thuốc nhuộm sau đó cho vi sinh vào. Sau 1 – 2 phút, đổ thuốc nhuộm đi và
rửa nhẹ bằng nước sạch tới khi nào thấy nước rửa chảy qua vết bôi không
còn màu nữa là được. Để tiêu bản khô dần hoặc thấm khô bằng giấy thấm.
Khi tiêu bản khô hẳn đem quan sát dưới kính hiển vi. * Nhuộm gram
- Quy trình nhuộm Gram cần chuẩn bị một số dụng cụ sau: đèn cồn,
que cấy, kính hiển vi, lam kính,…
- Hóa chất cần dùng cho quy trình là:
+ Dung dịch tím Gentian : thành phần gồm tím gentian nồng độ 1/10 ,
cồn 95 độ, acid phenic và nước cất.
+ Dung dịch Lugol : có chứa iod và kali iot. + Dung dịch cồn 90 độ.
+ Dung dịch đỏ Fushin kiềm: thành phần gồm Fushin kiềm, cồn 95 độ, acid phenic và nước cất.
- Quy trình nhuộm Gram bao gồm các bước như sau: + Bước 1: Tạo vết bôi.
Đánh dấu lam kính. Nhỏ 1 giọt nước muối sinh lý lên lam kính.Lấy vi
khuẩn từ các môi trường đã nuôi cấy bằng que cấy sau đó dàn đều trên
lam kính với nước muối sinh lý.
+ Bước 2: Cố định tiêu bản bằng cách để cách ngọn lửa đèn cồn
35cm.Mục đích việc cố định tiêu bản: để giết chết vi khuẩn, giúp vi
khuẩn gắn chặt vào lam kính và bắt màu thuốc nhuộm tốt hơn.
+ Bước 3: Nhuộm tiêu bản:
Phủ kín vùng có vi khuẩn trên lam kính bằng thuốc nhuộm tím kết
tinh trong thời gian 60 giây, sau đó rửa lại bằng bình tia. Mục đích: để
vi khuẩn thấm đều màu thuốc nhuộm.
Sau đó,phủ thuốc nhuộm lugol trong 1 phút, sau đó rửa lại bằng bình
tia.Mục đích: bước này giúp vi khuẩn giữ màu thuốc nhuộm tím kết tinh tốt hơn.
Tiếp theo,tẩy cồn bằng cách phủ cồn 90 độ lên lam và giữ trong 5-10
giây cho tới khi vừa mất màu và rửa lại nước bằng bình tia. Mục đích:
đây là bước tẩy màu, nếu trường hợp là vi khuẩn gram âm nó sẽ hòa
tan lớp màng lipid bên ngoài. Cần tẩy màu kỹ để vi khuẩn bắt đúng
màu thuốc nhuộm tránh nhận định kết quả sai.
Cuối cùng phủ thuốc nhuộm Safranin lên lam và giữ 60 giây sau đó
rửa lại bằng bình tia. Mục đích: giúp các vi khuẩn không bắt màu tím
sẽ bám màu hồng của thuốc thử này.
+ Bước 4: Quan sát kết quả
Để lam khô tự nhiên và soi trên kính hiển vi ở vật kính dầu x100. Đọc kết quả nhuộm
Vi khuẩn Gram dương: bắt màu tím.
Vi khuẩn Gram âm: bắt màu hồng. 18
V. Kết quả và biện luận kết quả Hình Nấm Mốc Hình Gram âm Hình Gram Dương
Qua các bước nhuộm màu gram vi khuẩn không bị mất màu khi nhuộm là
vi khuẩn gram dương, còn vi khuẩn bị mất màu trong lúc nhuộm là vi khuẩn gram âm. 19
Buổi 5. Cấy giữ giống vi sinh vật trong ống nghiệm I. Mục đích
- Để tạo ra đồng nhất một chủng VSV thuần khiết từ một tế bào riêng lẽ ,
phục vụ cho các công đoạn nghiên cứu đặc điểm , hình thái , nhuộm màu của từng chủng VSV . II. Nguyên tắc
- Sau khi thực hiện cấy phân lập và cấy truyền làm thuần nhiều lần , ta thực
hiện cấy truyền vào ống nghiệm . Ta thực hiện cấy truyền làm thuần bằng
phương pháp cấy ria và cấy điểm qua ống nghiệm môi trường mới
III. Tiến hành thí nghiệm
Bước 1: Đun chảy môi trường, sau đó cho môi trường vào ống nghiệm và hấp tiệt trùng.
Bước 2: Sau khi hấp tiệt trùng xong để ống thạch nghiêng và chờ thạch đông lại.
Bước 3: Sử dụng que cấy đầu tròn thực hiện các thao tác cấy với vi
khuẩn,nấm men,còn que cấy đầu móc dùng với nấm mốc.
- Cấy ria dùng của nấm men và vi khuẩn
- Cấy điểm dùng cho nấm móc
- Tay trái cầm hai ống nghiệm: 1 ống giống; 1 ống môi trường.
- Tay phải cầm que cấy và khử trùng trên ngọn lửa đèn cồn cho đến khi nóng đỏ dây cấy.
- Dùng ngón út và ngón áp út kẹp nút đậy ống nghiệm vào lòng bàn tay
xoay nhẹ, kéo nút đậy ra.
- Hơ nóng để khử trùng không khí ở miệng hai ống nghiệm.
- Đợi khi que cấy vừa nguội, khéo léo đưa que cấy tiếp xúc với khuẩn lạc trong ống giống.
- Lấy khuẩn lạc đó cấy vào ống môi trường đã chuẩn bị sẵn.
- Cấy ria dùng của nấm men và vi khuẩn
- Cấy điểm dùng cho nấm móc
IV. Kết quả và biện luận kết quả 20